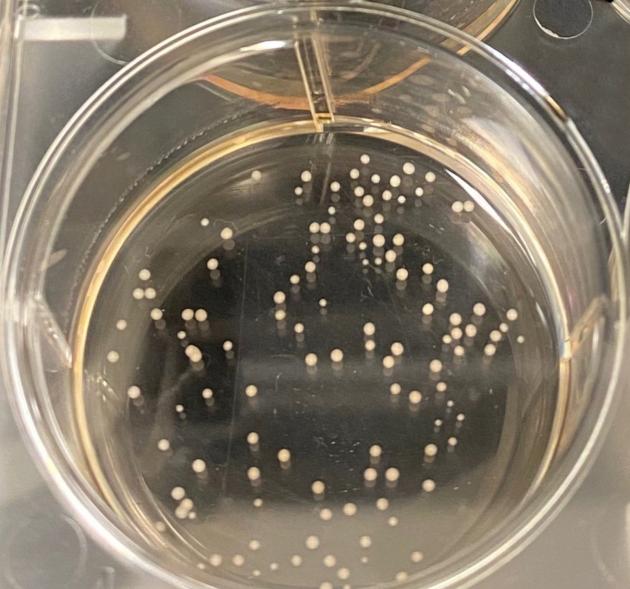

专访黄琦|为「脑类器官」开发「脑机接口」研究神经行为,正计划申请专利和产业转化,或将打造精准医疗药物筛选平台
收藏
关键词:
药物器官专利神经精准医疗医疗打造专访药
资讯来源:DeepTech深科技 + 订阅账号
发布时间:
2022-10-17

类器官是由动物或人体干细胞分化和培育得到的一种小型器官组织,可用于多种疾病模型的研究、药物测试,甚至取代患者受损器官组织等。截至目前,科学家已经成功培育出人类的肺、肠道、肝脏、胰腺、肾脏以及大脑等类器官。
脑类器官是模拟人类大脑结
构功能和研究神经系统疾病的重要模型。微电极阵列能够检测和记录脑类器官细胞的电生理活动,是研究脑类器官的重要工具,然而,传统的电极阵列大都是二维结构,只能测量培养皿中的神经细胞或脑类器官的有限区域。
▲图|一种微型脑类器官(来源:Johns Hopkins University)
前不久,约翰·霍普金斯大学研究人员发表了一篇研究论文,展示了一种
“微型脑电帽”,能够将脑类器官进行包裹并检测脑电活动信号,可以更好地探索神经系统疾病以及危险化学物质对大脑产生的影响。
近日,生辉对该论文一作、约翰·霍普金斯大学黄琦博士进行了采访,围绕这项研究成果的发现、过程和意义进行详细解读。
▲图|约翰·霍普金斯大学生物化工系黄琦博士(来源:受访者)
黄琦本科就读于天津大学,毕业后他进入美国约翰·霍普金斯大学读硕士,研究方向为 DNA origami(DNA折纸技术)。目前,黄琦即将在约翰·霍普金斯大学生物化工系取得博士学位,博士期间他的研究方向主要是通过设计和制造可折叠的电子器件来实现对于生物类器官的电生理信号测量。
“当时我们课题组的研究方向主要是对一些很薄的材料进行折叠并开发其功能应用。作为目前已知最薄的材料之一,石墨烯自然而然地就引起了我们的关注。”黄琦介绍说,“此前,也有很多研究人员基于石墨烯折纸技术开发一些光电器件,通过新维度的引入,发掘石墨烯的新应用。”
(来源:Advanced Intelligent Systems)
在那项研究中,他们通过转换溶剂,能够
在微小尺度下实现石墨烯材料的可逆自折叠。
“由于石墨烯是单层结构,我们通过叠加单层石墨烯得到一种“卷积”结构。基于石墨烯材料的光电性能,我们成功开发出了一种可以响应光信号和电信号的微型光电探测器。然后,我们又折叠出一些更为复杂的结构,进而实现更多功能,比如对光源角度的测量等。除此之外,我们还把这种石墨烯结构自折叠做在了硅板上。”黄琦表示。
据介绍,在此之前开发的三维自折叠结构器件很难和基底结合起来,也就是处于
‘游离
态’
,因此难以实现更多功能拓展,比如与其他装置或通路的联接等。“所以我们开始尝试将这种自折叠结构和硅板结合在一起,这样就能
拓展更多功能和应用。
”他指出。
▲图|石墨烯三维自折叠结构和光电信号探测(来源:Advanced Intelligent Systems)
在自折叠结构的制造过程中,他们遇到的最大挑战是如何实现“自折叠”。“我们课题组之前开发的方法难以应用在复杂的结构上,并且其折叠方向也存在局限性。于是我们对加工工艺进行了优化和改进,并创新采用石墨烯和 SU-8(一种被广泛应用于微流控和微电子领域的光刻胶)双层结构来进行制作,从而让折叠过程变得可控。”黄琦介绍说。
通过先前的探索,黄琦和团队积累了经验,于是他们便着手开展新的研究,而这也就是今年 8 月发表在 Science Advances 上的新研究成果——为脑类器官开发的一种“微型脑电帽”。
据了解,这种脑类器官是一些直径约 500µm 的三维球体。“相较于培养皿中的二维神经细胞而言,具有三维结构的脑类器官是一种更好的工具,它可以
更为真实地模拟大脑或神经的运作机制
,毕竟,
神经细胞在不同的微环境中所表现出来的行为也会不一样。
”黄琦指出。
对脑类器官的研究,传统方式是采用微电极阵列,但
传统微电极阵列是二维平面结构,难以满足对三维脑类器官的研究需求。
“如果我们想要完整了解到三维的脑类器官在进行什么电生理活动,需要
把电极
包裹在脑类器官的表面
,或者深入到脑类器官内部,这样才能够获取更为全面和详细的电信号。”他说道。
在这项新研究中,他们开发出一种可以自折叠并包裹住脑类器官并对其进行测量的新型微电极阵列,可以最大程度、实时获取类器官细胞电信号。
这种微电极阵列的折叠基础是一个
双层的高分子结构
,上下两层材料的交联程度不同,在有机溶剂(如丙酮)中处于展平的状态,而当把溶剂转换为水(或细胞培养液)之后,上层材料由于应力而收缩,随着时间推移,上层材料比下层材料收缩程度更为严重,最终实现电极的自折叠。
“通过调控双层材料所需的应力差来调节折叠的程度,可以正好把脑类器官包裹起来
。”
黄琦说道。
▲图|三维微电极阵列加工制作流程(来源:Science Advances)
据介绍,他们首先对微电极阵列进行无菌化处理,然后在其折叠到一半的时候把脑类器官放入其中,微电极阵列继续折叠直到把脑类器官完全包裹起来,从展平状态到折叠完成整个过程大约耗时 1 小时,相对缓慢的折叠过程能够保证不会对脑类器官造成机械损伤,包裹完成后,即可对脑类器官的电信号进行检测。
“试验显示,这种微电极阵列能够实现高信噪比和三维时空信号记录。目前而言,我们检测到的信号大体上可以分为两种,一种为
局部信号
,即只有部分电极可以探测到,表明此时,这个信号只是限制在了特定的区域;另一种为
全局信号
,即所有电极都可以探测到,表明整个类脑器官的信号在此时具有同步性,这也意味着整个脑类器官的神经网络是同步的。当然这也只是最初的观察。”黄琦说道。
“将‘类器官+检测器’打造成精准医疗药物开发平台”
在黄琦看来,脑类器官其实是一个比较新兴的领域,它很有可能会
逐步取代现阶段所进行的一些二维神经细胞培养研究
,因为它更接近于真实的人体微环境状态,而且还有潜力
取代一部分动物试验。
“因此,为各种不同的类器官配套制作出与之相对应的检测工具显得至关重要,但就现阶段而言,传统器件并没有很好的满足这个需求,比如,测量三维类器官结构需要相匹配的三维电极。”黄琦表示。“我认为这项研究的核心价值,是
为日益发展的类器官研究工作提供了一个较为可靠的检测工具。
”
作为脑类器官的“脑电帽”,这种
三维微电极阵列其实也是一种
脑机接口。
相较于传统意义上的脑机接口,黄琦表示,“两者在研究上存在交叉,一个区别是
电极尺度大小
不同,传统脑机接口电极,比如EEG,对于微电极阵列而言是一个庞大的结构。另外,相比于脑类器官,目前科学界对大脑的研究相对成熟,已经确定了哪些脑区拥有何种功能,于是就可以有针对性地检测特定的脑区并进行信号分析,而现阶段对于脑类器官的相关研究才刚刚起步。”
不论是脑机接口还是三维微电极阵列,这些器件都是直接与生物体接触的,对于材料的选取,黄琦指出,“
生物相容性
是第一位的,比如在这项试验中所使用的 SU-8 材料就拥有较好的生物相容性;其次是
柔性材料
,因为不论是人的大脑还是脑类器官,它们都是非常柔软的组织,在这项研究中所采用的电极材料 PEDOT:PSS 是一种柔性电极,其相较于金属电极更为柔软。”
▲图|石墨烯三维自折叠结构制造流程(来源:Advanced Intelligent Systems)
关于这项研究的创新方面,黄琦总结了三点,“首先,学术界很少有开展相关研究,即
专门为脑类器官制作一种“脑机接口”
;其次,我们采用的创新方法能够让电极刚好针对脑类器官进行包裹和测量,未来如果能进入到批量生产阶段,它将会是一种
探索神经行为的有力工具。
此外,这种三维微电极阵列结构还
可以根据目标类器官的形状和大小来进行相应地调整
,从而实现对各种类器官的检测。”
谈及这项研究的产业转化,“我觉得目前来说,这种微电极阵列主要是
用于神经系统的研究
,因此我们产业化的方向主要是
面向科研领域
,如研究各种类器官的科研人员。”他说道,“目前,我和导师 David Gracias 教授也
正在考虑申请一个专利,然后寻找一些传统做电极阵列的公司开展合作,把这种新工具进行产业化。
”
未来,随着类器官的不断深入和发展,微电极阵列作为一种研究工具也将更有“用武之地”。“
类器官和三维微电极阵列检测器件可以有机地结合起来,打造成一个试验平台。
基于此,我们开发的微电极阵列检测器可以应用于
基因疗法、精准医疗
等,比如提取病人细胞培养相对应的类器官,通过类器官和检测器对患者进行个性化的药物筛选和精准治疗。”黄琦总结道。
3.https://graciaslab.johnshopkins.edu/index.html
4.https://hub.jhu.edu/2022/08/17/brain-organoids-mini-grippers/












 药选址
药选址